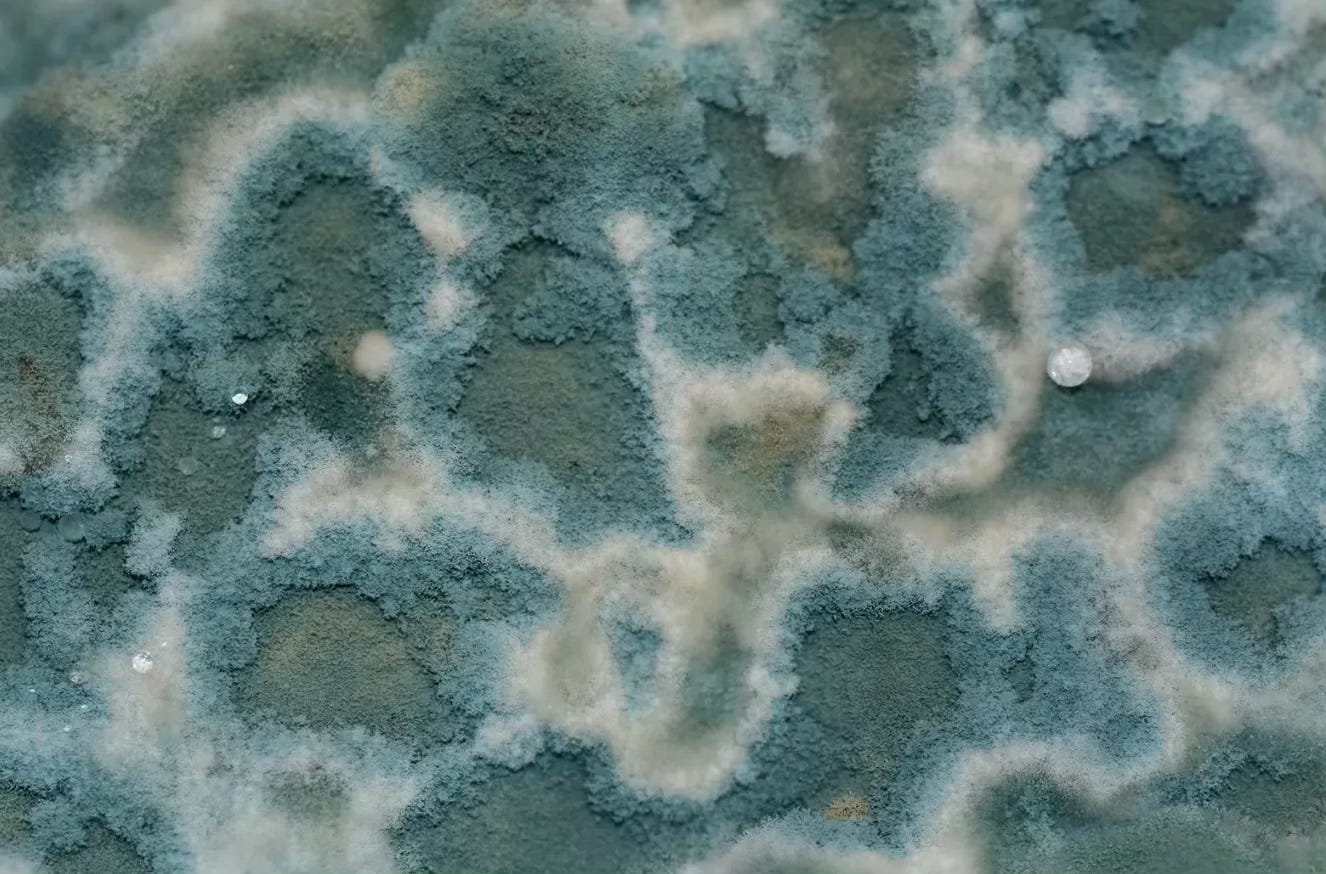

Mycotoxines : comment je m’en suis débarrassée en 4 mois 🧬
Il y a quelques mois, j’ai fait un test pour détecter les mycotoxines dans mon corps — et les résultats étaient… choquants !
J’avais partagé mes résultats inquiétants dans cet article :
⚠️ Moisissures Cachées : le Poison Silencieux qui a Failli Briser ma Santé de Biohackeuse
·
En tant que biohackers, nous optimisons sans cesse, nous mesurons, nous ajustons notre biologie pour la performance et la longévité.
J’ai découvert des taux dangereusement élevés de quatre mycotoxines différentes. Tout mon graphique était rouge.
Et comme vous le savez, le rouge n’est jamais bon signe — ni dans la nature, ni dans les analyses.
Il fallait que je les élimine. Mais attention à certains dangers si le protocole est mal établi ! Lisez bien jusqu'en fin d’article où je mets en évidence le plus gros danger.
Continuez votre lecture avec un essai gratuit de 7 jours
Abonnez-vous à Guide Ultime du Biohacking & de l'Anti-Âge pour continuer à lire ce post et obtenir 7 jours d'accès gratuit aux archives complètes des posts.